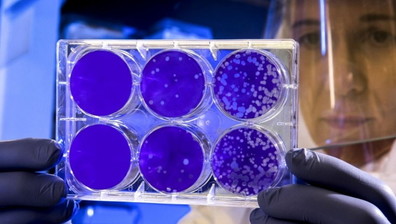

avellino
Si sveglia dal coma... con la tessere del Pd: denuncia e terremoto politico

ai domiciliari
Suora rubava oro e gioielli. Scandalo in Curia, dove finivano i soldi

Famiglia arcobaleno
"Presepe con due Marie": Natale e tradizioni stravolte, l'ultima follia

avellino
Muore dopo la cena al ristorante: sospetti sull'ingrediente killer

Altro alluvione
Il maltempo devasta l'Italia: la bomba d'acqua mortale ad Avellino | GUARDA

roberto bembo
Finisce nel peggiore dei modi l'accoltellamento di Capodanno vicino Avellino

avellino
Lamette e urla, agenti ostaggio dei detenuti: terrore nel carcere

nuovo ricovero
De Mita grave in ospedale. Il drammatico post della figlia: "È solo con il suo medico"

Strage sfiorata
Folle piano omicida di due fidanzati di Avellino: un morto, ma volevano sterminare tutta la famiglia
avellino
Vanno al funerale ma la madre del defunto è positiva. Ottanta in isolamento

paura
Terremoto vicino Avellino. Quattro scosse fanno tremare l'Irpinia

basta con i pagliacci
Festa, De Luca e l'ignobile show di una politica vuota

movida e covid
Ad Avellino fanno Festa, e lo sceriffo De Luca che dice?

tutti assembrati
Il sindaco di Avellino è l'anima della Festa: movida e cori alla faccia del virus | VIDEO

EMERGENZA CORONAVIRUS
Il designer irpino che produce e regala materiali protettivi agli ospedali

blitz
Coprifuoco da coronavirus. Così la polizia pizzica tre ragazzi in strada

il prefetto: stato di emergenza
Fabbrica di batterie a fuoco: fumo tossico ad Avellino [video]

avellino
Scoppia una bombola, coppia di Uomini e donne in ospedale

strage di avellino
Bus nella scarpata, assolto l'ad di Autostrade L'ira delle famiglie in tribunale [video]

A Nusco, Avellino



